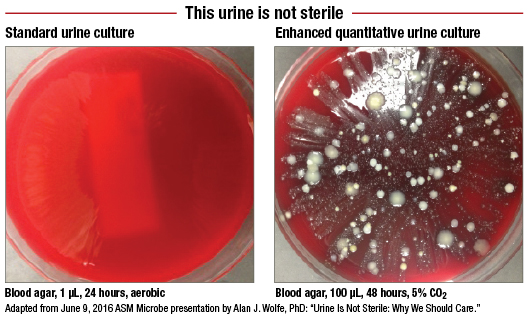
figure1

Kevin B. O’Reilly
August 2016—The long-held belief that urine is sterile is facing a serious challenge from new research combining sequencing techniques and an enhanced urine culturing protocol to uncover an array of uropathogens hitherto unseen in microbiology laboratories.
The notion that urine, indeed the entire bladder, is sterile is one medical students are still taught and “it’s a pretty deeply entrenched dogma,” says Linda Brubaker, MD, a urogynecologist and professor of obstetrics and gynecology and urology at Loyola University Chicago Stritch School of Medicine. She and a team of Loyola colleagues have worked for years to learn more about urinary microbiota and in the process demonstrated that currently standard urine culturing techniques fail to spot an alarmingly high proportion of uropathogens that may well be clinically relevant. Their findings were presented in June at the American Society for Microbiology’s Microbe meeting.

“What we’re going to do is replace the dogma that clinical care is based on,” Dr. Brubaker says. “There is a great deal of excitement because this is a vast unknown. It’s like discovering a tribe in the middle of the Amazon. We never knew these people were here, or how they eat, or how they live. We have to understand this [bacterial] community now—how it maintains health, how it deals with perturbations, like when patients are catheterized and a certain number of patients will get infections. Not all of them do. We may learn why some do and some don’t.”
The longer-term research and clinical implications of the finding that urine is not sterile could be profound, leading to a better understanding of what causes myriad urologic conditions. Most immediately striking are the implications for clinical microbiology laboratories and clinicians struggling to help patients with recurrent urinary tract infections.
A protocol developed at Loyola and dubbed the enhanced quantitative urine culture, or EQUC, tests a much larger volume of urine in a CO2-enriched environment over two days, twice as long as the standard 24-hour urine culture. What EQUC uncovers that the standard urine culture misses comes as a bracing affront to the sterile-urine hypothesis.
In a study involving 150 female patients who were asked, “Do you feel you have a UTI?” those enrolled were split evenly between patients who answered yes and those who answered no. Urine specimens from the patients were tested using the standard urine culture (1 µL of urine, blood agar plate, MacConkey agar, incubated 24 hours in aerobic conditions at 35°C) and a variety of other culturing approaches. The latter included what the Loyola team calls the “streamlined EQUC” (100 µL of urine, BAP, MacConkey agar, CNA agar, incubated 48 hours in five percent CO2 air at 35°C).
The standard urine culture detected just 33 percent of 182 uropathogens, while the streamlined EQUC protocol spotted 84 percent of the uropathogens. But how many of those uropathogens make a clinical difference in patients? This is why patients were asked about their symptoms. In the group reporting UTI symptoms, the standard urine culture detected only 57 percent of uropathogens, while the EQUC spotted 91 percent (Price TK, et al. J Clin Microbiol. 2016;54[5]:1216–1222).

This finding is “very significant,” says Robert Sautter, PhD, the recently retired director of microbiology for the Carolinas Pathology Group that serves the massive Carolinas HealthCare System.
“It’s one of the biggest things I’ve seen in urine cultures in the last 20 years, and the reason is that we now think we’re missing all these infections, the causative agents—67 percent by their numbers. That’s amazing. That’s worse than flipping a coin. And if we can close that gap a little bit, that’s an enormous thing,” says Dr. Sautter, who now works as a clinical microbiology consultant in Lancaster, SC, and presented an unrelated talk on direct detection methods for diagnosing UTIs at the ASM meeting.
The Loyola team “is showing things we did not know in the past,” adds Dr. Sautter, who was not involved in their research. “We’ve known about breakpoints in colony counts, that for certain diseases were different, for 50 years. Some people followed it and some people didn’t. But now we’ve got an indication that maybe we’ve missed the boat over these 50 years and we are missing some clinically important infections with these organisms that are not being detected.”
The false-negatives with the standard urine culture appear to have an impact on patient outcomes, Alan J. Wolfe, PhD, said in his presentation at the ASM Microbe meeting. Dr. Wolfe is a professor of microbiology and immunology at Loyola and co-director, with Dr. Brubaker, of the Loyola Urinary Education and Research Collaborative.
Following up with patients after treatment, researchers discovered that 61.5 percent of those found positive for a UTI by both standard urine culture and EQUC—and thus treated with antibiotics under the prevailing standard of care—saw their symptoms improve. Another 30.8 percent said their UTI symptoms stayed about the same, while 7.7 percent said they felt worse.
By contrast, among patients who were negative by the standard urine culture but positive by EQUC—and thus received no antibiotics—only one-third reported UTI symptom improvement. The other two-thirds of these patients said their symptoms stayed the same or grew worse with time.
“So the question, of course, is would they have improved if they were treated?” Dr. Wolfe said. “Another question would be this. Here you have some individuals that were standard urine culture-positive and they were treated, but they didn’t improve. Is that because there were uropathogens underlying the suspected broad uropathogen that was treated?”
These and other questions about the patient impact of the EQUC protocol are ones the Loyola team hopes to answer with a clinical trial for which enrollment will begin later this year. The researchers have developed a different treatment algorithm for patients whose urine tests positive by EQUC (but negative by the standard urine culture) to see what, if any, improvement can be seen in the course of their UTIs.

“We are beginning a double-blind study of women who come into the clinic and who feel they have a UTI,” says Paul Schreckenberger, PhD, director of clinical microbiology at Loyola University Health System and a professor of pathology at Loyola’s medical school. “We will divide them into two groups. Group A will get the expanded culture done. The physicians will get that report and they will be asked not to prescribe anything until they get that lab report back. The woman’s going to be told to give a urine sample today and they will get a call in a day or two and we’ll know if we want to treat you or not.
“Then group B will get the standard two-plate culture. Those physicians will only see the results that are the current standard of care and then decide to treat or not to treat. Then, 10 days later both groups will be followed up with in a phone interview to see if their symptoms have resolved, and they will be asked to come back in for a repeat culture.”
For the new organisms found in the EQUC, clinicians will be provided with a list of drugs previously found to be effective.
That is necessary, says Dr. Schreckenberger, “because physicians weren’t trained to treat those bugs, and they might not be comfortable with the treatment protocols.” He and a team of ob-gyns developed the new treatment options “based on a review of the literature and what drugs are reported to work on these new bugs.”
 Now on the cusp of potentially changing the way a vast swath of UTIs are diagnosed and treated, the effort at Loyola began as a modest series of bull sessions between Drs. Brubaker and Wolfe.
Now on the cusp of potentially changing the way a vast swath of UTIs are diagnosed and treated, the effort at Loyola began as a modest series of bull sessions between Drs. Brubaker and Wolfe.
“What I really do for a living is take apart E. coli to understand the circuit board inside the cells,” Dr. Wolfe tells CAP TODAY. “How does it know how to respond appropriately to its environmental stresses? I’m a geneticist, and I use little genetic scissors to clip the insides of cells to see what kind of chaos I can create. That research is used by others to develop products and bacteria. I recognized that I could use my talents to try to address something that was a little more clinically immediate.”
About a decade ago, Dr. Wolfe got word that Dr. Brubaker, “an excellent clinician,” would be a good person for him to talk with.

“I walked up to her and said, ‘We have two words in common: E. coli. I study it, and you want to kill it,’” Dr. Wolfe said. So began a fruitful set of talks. During one of them, Dr. Brubaker mentioned the standard belief that the bladder is sterile.
“I had heard that as a private citizen and I let it wash over me and I said, ‘Yeah, OK.’ But when it was said to me in my role as a microbiologist who had studied bacterial motility and chemotaxis as well as biofilms, I said, ‘No way.’ So we decided that we’d test the dogma.”
Dr. Brubaker says she had long been skeptical of the view that the bladder is sterile.
“It never really made sense to me. The female urethra is three to four centimeters long, and it is not very far inside the body. Given the environment with the vagina and the bowel-rich bacterial environment in the body, how could something that is only three centimeters away be sterile?”
So how did that belief take hold?
“That has risen to the level of dogma because when the standard urine culture comes back showing no growth, clinicians assume there are no bacteria there,” Dr. Brubaker says. “That had been reinforced with a poor test that was honed for very different reasons in the 1950s and developed to detect bacteria that could give people kidney infections. That is not a good test just to detect if bacteria are there.”
Dr. Wolfe realized that next-generation sequencing could help resolve the question. He and his team extracted DNA from ob-gyn-provided urine samples, then amplified and sequenced the 16S ribosomal RNA gene and followed this with taxonomic analysis. A key question was whether the bacteria found by sequencing actually reflected bacteria in the bladder as opposed to vulvovaginal contamination. The team tried to address that by studying samples collected by transurethral catheter (TUC) and comparing those with samples collected by suprapubic aspiration (SPA) and the controls—including samples of voided urine.
The sequencing found plentiful bacteria in the samples collected by TUC and SPA, and they “look very similar to each other,” Dr. Wolfe said, and neither resembled the controls. “Since the SPA bypasses the vagina and the TUC sample looked like the SPA sample, we decided that we had evidence that we could use TUC samples for the rest of our studies. And then we had the DNA evidence that bacteria were really present in the bladder.”
“But,” Dr. Wolfe added, “we didn’t know whether they were alive. So this is where Dr. Schreckenberger’s expertise came in.”
When bacterial DNA was found in urine samples by sequencing—Actinobaculum, Bradyrhizobium, Gardnerella, Lactobacillus, Staphylococcus, and Streptococcus, among others—Dr. Schreckenberger knew “these are all organisms we should be able to grow, but we wouldn’t be able to grow them under normal conditions that we use.” With the standard urine culture, “we are looking for E. coli, Proteus mirabilis, and Enterococcus, which cause 90 percent of all UTIs. So the culture conditions are essentially honed to grow those three organisms.”
Dr. Schreckenberger was surprised when Dr. Wolfe showed him the results of his bacterial DNA sequencing.
Dr. Schreckenberger was surprised when Dr. Wolfe showed him the results of his bacterial DNA sequencing.
“I thought, like everybody thought, that urine was sterile except when there’s an infection,” he says. The Loyola team tried more than two dozen different combinations of atmospheric conditions, media, incubation times, and urine volumes before arriving at the streamlined EQUC. The process of studying each of these and seeing under which conditions the uropathogens grew best took about a year.
“We got the bacteria right at the start, but where it didn’t show up was on the standard plates,” Dr. Schreckenberger says. “Even if we took standard plates and kept them in the carbon dioxide incubator, they just weren’t growing.”
The other big change in the culturing protocol, described earlier, was to increase the amount of urine plated. “We thought maybe these organisms are present in lower volumes.”
The process was so time-consuming because “every time something grew we had to identify it. I might culture you and get five different bacteria. And then I culture your neighbor and get five bacteria different from you. Now I’d better do a third patient to see if there’s any more.”
At the ASM Microbe meeting, Dr. Wolfe summarized what the Loyola team and others have learned since publishing their first peer-reviewed article on “evidence of uncultivated bacteria in the adult female bladder” (Wolfe AJ, et al. J Clin Microbiol. 2012;50[4]:1376–1383).
“First of all, the female urinary microbiota [FUM] exist, and they’re alive,” he said. “Some of the members of the FUM are associated with lower urinary tract infection symptoms, in particular urgency urinary incontinence [UUI], which is the incontinent version of overactive bladder syndrome. Others are associated with a lack of UUI symptoms in continent controls.
“And the FUM can be associated with a response to medication,” he added. “We also show that the FUM is associated with post-instrumentation UTI and postoperative UTI. The FUM influences the innate immune system of the urothelium, and we recently published a paper showing there are microbiota associated with calcium oxalate kidney stones.”
And there is so much more to learn, Dr. Brubaker says.
“What are the characteristics of healthy microbiota?” she says. “We can be different, and health can look different and bacterial communities can look different in health based on age, sexual activities, medications, etc. We need to understand the parameters of health, which bacterial communities are vulnerable, and how do they catch urinary tract infections and other problems. And after those infections or whatever, how do they restore themselves to a state of health? We don’t have that information yet. We don’t know which common conditions that we never thought were bacterial may be bacterial or have a bacterial contribution.”
The Loyola team says audiences such as those at the ASM Microbe meeting have been the most receptive to their findings on the urinary microbiome. But skepticism remains.
“There’s a threshold for people to get over,” Dr. Brubaker says. “They have to be convinced that this isn’t all contamination. They note that Lactobacillus lives in the vagina and [they] say you’re just measuring something that lives in the vagina. It’s true that it lives in the vagina, but it’s also been demonstrated that it lives in other places. Researchers are accepting it, but it’s a hurdle among some clinicians.”
Dr. Wolfe says it’s difficult for people to give up deeply held beliefs. “We’re turning the world of the bladder upside down at this point. The way I look at it, everything we think we know about the bladder has to be re-evaluated because a fundamental assumption—it was sterile—is wrong.”
More narrowly, the Loyola team’s findings on the inadequacy of standard urine culture deserve more study, says Dr. Sautter, the clinical microbiology consultant.
“They’ve made an enormous step in the right direction in telling us, ‘Hey, wait a minute, this is what we know now, but things are changing.’ They never find what’s causing the UTI. They treat the patient and they may or may not get better, or they don’t treat the infection and it retrogrades, causing sepsis. To me, this is really huge.”
Dr. Sautter adds that “there needs to be numerous centers that do” EQUC to show its advantages over standard urine culture. “It can’t just come from one center.”
He commends the Loyola team for moving to the next logical step with their clinical trial to evaluate how the EQUC can affect treatment choices and patient outcomes. As for whether other microbiology laboratories ought to adopt the EQUC, he says: “At this time, I’d say this is something to do in parallel and take a look at it.” Implementing the enhanced urine culture “will take significant time” for other laboratories, especially if they do not already incubate their urine specimens for 48 hours.
Loyola’s further research, and efforts to replicate the work in other settings, will answer the question of “what’s the bang for the buck,” Dr. Sautter says, estimating the EQUC could be “two or three times the work” it takes microbiology labs to do standard urine cultures.
“Are we going to detect infections, or are we detecting contaminants?” he says. “We need to know that and find that out.”
Dr. Schreckenberger acknowledges the challenges for microbiology laboratories that might be interested in implementing the EQUC into their workflow.
“It’s not just the different dilutions of urine, but incubating the plates longer, and the carbon dioxide atmosphere. It’s more work for the lab,” he says. “Then if you are going to grow things that physicians aren’t used to seeing in their reports, you may be reporting names of organisms that they don’t associate with UTIs. They know Enterococcus, and now you’re saying there are all these other organisms and what do I [the clinician] do with that? Is that important?
“In that regard,” he adds, “it’s controversial. In fact, if these bacteria are normal flora, then we probably shouldn’t be doing anything with them and they’re supposed to be there. That’s where we are now with our work. When we grow all these additional bacteria, we’re asking which are the ones that are normal and supposed to be there, and which are contributing to patient symptoms.”
There is yet another practical roadblock to the EQUC making a dent in treatment of UTIs. At the ASM Microbe meeting, an audience member brought it to the fore, asking Dr. Wolfe about the bottom-line impact of the EQUC findings when so many cases of UTI are treated empirically by clinicians who skip ordering a urine culture.
“I’m completely aware of that behavior,” Dr. Wolfe said in response. “As a scientist, it bothers me because there’s no evidence that the patient has a bacterial infection. I can’t make doctors get a culture. They’re going to do what they are going to do. But hopefully, by providing more information about what’s really there, practice might change.”
Dr. Brubaker also is hopeful the Loyola team’s work could lead to a reduction in empiric treatment and, consequently, needless antibiotic prescribing for suspected UTIs.
“We are probably overtreating people, and overtreating them with something for which we don’t appreciate the collateral damage,” she says. “The algorithm of, ‘Oh, they have the typical symptoms and they had a UTI before so, here, eat these pills,’ that algorithm of casual antibiotic dispensing lacks precision and we need to do better. It’s expedient for the doctor and that’s why it is deeply entrenched.”
Even if the EQUC’s benefits for patients are proven, urging clinicians and patients to wait at least 48 hours for results before prescribing may be an uphill battle.
“Here’s my fantasy,” Dr. Wolfe said. “What we’d really like to do is to identify which organisms are really the ones doing harm and then figure out what their genetic signatures are. And then we do lab on a chip. It’s distinctly possible. I’d love to be able to have, for example, individuals who come in for bladder surgery . . . and while the clinician’s prepping the patient, we get 1 µL of urine on one of these microfluidic devices. And by the time they are finished 15 minutes later, they know whether this was a community of bacteria that put that individual at risk for a postsurgical UTI.
“That’s where we’re trying to get to,” Dr. Wolfe said. “We’re certainly not there. First, we have to see. If you don’t look, you don’t find.”
[hr]
Kevin B. O’Reilly is CAP TODAY senior editor.

